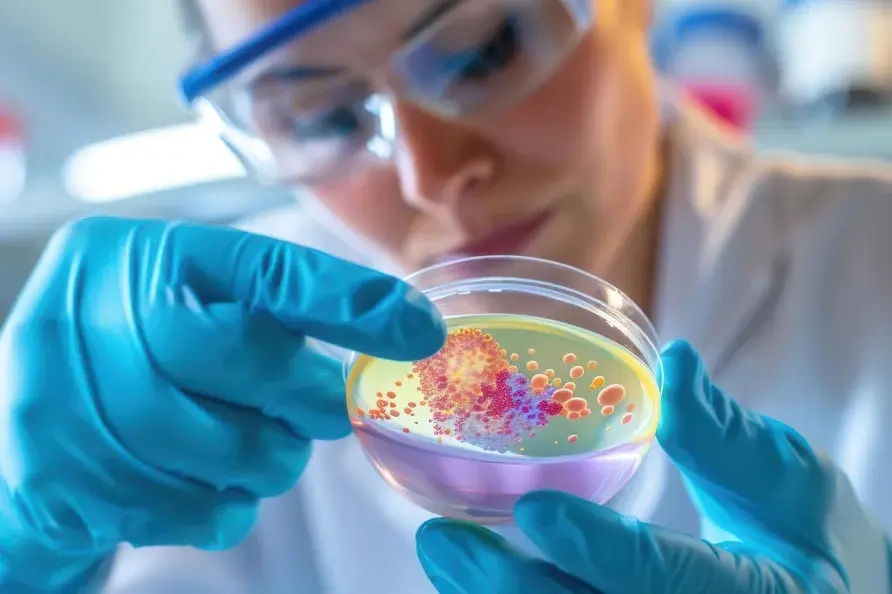
実験室でシャーレ内の微生物を精密に検査する研究者

アントロキノノールについて
健康維持への可能性が注目される成分
アントロキノノール
アントロキノノール(Antroquinonol®)は、Golden Biotechが発見したベニクスノキタケ由来の成分で、健康維持を支える可能性が研究されています。特に抗がん分野では、がん細胞の増殖に関わる仕組みに着目した基礎・前臨床研究が進められ、その働きが注目されています。
アントロキノノールの概要
2006年にGolden Biotechの研究チームによって発見されて以来、分子が小さく独自の構造を持つことから注目され、2007年には国際的な学術誌「Planta Medica」に研究成果が掲載されました。
この成分は、ベニクスノキタケをもとに作られており、原料となる菌種は高度な分析技術を用いて厳密に確認されています。多くの近縁種と比較しながら検証することで、品質と信頼性を大切にした製造が行われています。

- 化学式
- C24H38O4
- 分子量
- 3390 g mol-1
- 色
- light Yellow camphorata
- 溶解度
- low solubility in water (< 0.1 mg/ml)
- 安定性
- 24 months (under 4 and 25 ˚C)
発見の歴史
-
2006年 ベニクスノキタケから
アントロキノノールを発見GoldenBiotechの研究チームが、ベニクスノキタケからアントロキノノールを初めて発見。
その化学構造、製造方法および用途が世界各国で特許として保護されています。 -
2015年 FDAのオーファンドラッグ指定を
取得し、本格的な臨床研究が進展膵臓がん、急性骨髄性白血病(AML)、肝細胞がん(HCC)などに対して米国FDAから
オーファンドラッグ指定(希少疾病用医薬品指定)を受けています。 -
2020年 COVID-19治療を含む多領域での
臨床試験・研究が実施・拡大2020年〜2022年頃、COVID-19の治療薬候補として臨床試験(Phase II)が進行。
FDAによる試験承認や試験結果の良好な成果が報告されています。
軽症〜重症患者を対象にした試験で安全性と効果が示され、拡大試験が許可されるなどの進展もありました。
アントロキノノールの作用機序
がん細胞の“増殖の合図”に、確かな歯止めを
アントロキノノールは、がん細胞の増殖シグナル伝達系に対し、最上流から作用することが確認されています。FPP(ファルネシルピロリン酸)の利用を阻害することで増殖を抑制し、最終的に二種類の細胞死(アポトーシスおよびオートファジー)を誘導するという、多角的な抗腫瘍メカニズムが期待されます。
01 FPPの結合を阻害し、
がん増殖スイッチをOFFに
01 FPPの結合を阻害し、
がん増殖スイッチをOFFに
がん細胞が増殖するためには、シグナル伝達のスイッチ役となる「Rasタンパク質」が活性化する必要があります。この活性化には、酵素(FTase)を使って「FPP(ファルネシルピロリン酸)」という物質をRasに結合させるプロセスが不可欠です。
アントロキノノールは、この酵素(FTase)に作用することで、FPPがRasに結合することを阻害します。 これにより、Rasは細胞膜に定着できず機能不全に陥ります。その結果、下流にあるがんの増殖シグナル伝達経路(PI3K/Akt経路など)が根本から遮断されます。
02 二重の細胞死誘導メカニズム
02 二重の細胞死誘導メカニズム
アントロキノノールは、増殖シグナルの遮断を通じて、がん細胞に「死のプログラム」を作動させます。
オートファジー(自食作用)による細胞死 細胞の代謝を制御するmTORC1の働きを抑制することで、がん細胞が自らの成分を分解してしまう「オートファジー」を強く誘導し、細胞死を引き起こします。
アポトーシス(プログラムされた細胞死) 増殖シグナルの停止により、細胞内のミトコンドリアを介した「アポトーシス」経路が作動。がん細胞を自滅へと導きます。